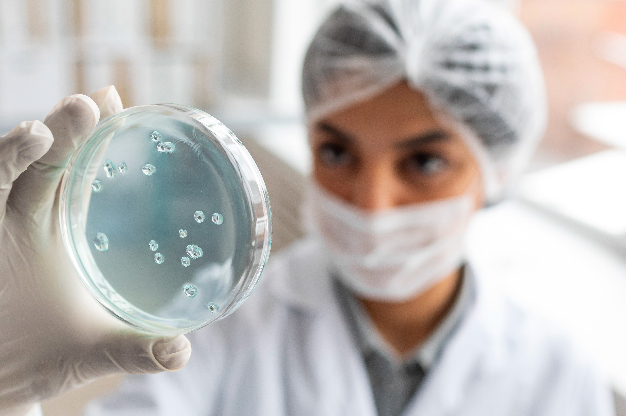

A qualificação profissional em Antibiograma: da Elaboração ao Laudo está com inscrições abertas. Interessados podem acessar o site unijui.edu.br/qualificacao-profissional e realizar sua inscrição até o dia 7 de agosto. O curso acontecerá no dia 20 do próximo mês e possibilitará aos participantes otimizar a elaboração, interpretação e laudo laboratorial do antibiograma.
O antibiograma, também conhecido por Teste de Sensibilidade a Antimicrobianos (TSA), permite identificar o microrganismo causador da infecção e sua sensibilidade aos antibióticos. Os resultados deste exame são interpretados e utilizados para tomar decisões sobre o tratamento, evitando, assim, o uso de antibióticos desnecessários e o surgimento de resistência ao medicamento.
De acordo com o professor da Unijuí, Matias Nunes Frizzo, o estudante poderá aplicar o conhecimento teórico por meio de práticas que serão realizadas nos laboratórios da Universidade. “Este é um diferencial, pois o curso possibilita que o participante compreenda o que significa esse exame e quais são as regulamentações internacionais acerca do antibiograma”, afirma.
A capacitação também traz atualizações sobre o que a comunidade científica constrói acerca do exame, que, segundo o professor, é fundamental pois potencializa o uso do medicamento de modo assertivo. “Dada a problemática da resistência aos antibióticos, anualmente nós vamos ter novos padrões para detectar se determinada bactéria é resistente ou não. Portanto, todos os anos temos que atualizar nossas atividades e o curso proporciona essa atualização”, destaca Matias.
Mais informações sobre esse e outros cursos de qualificação profissional ofertados pela Unijuí, entre em contato pelo telefone 55 3332 0553 ou pelo e-mail educacaocontinuada@unijui.edu.br.
Gabriel R. Jaskulski, acadêmico de Jornalismo da Unijuí